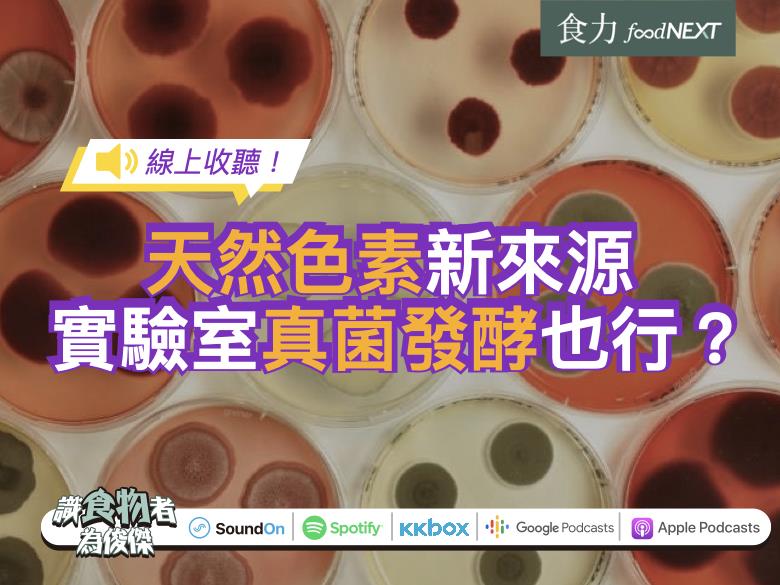

你應該要知道的食事
現在連在實驗室也能產出天然色素?在丹麥就研發出一種真菌發酵製成的天然紅色色素,不僅靠實驗室就能生產?
主講人=食塔奇
天然色素來源包括植物甚至昆蟲都能從中取得。不過現在連在實驗室也能產出天然色素?在丹麥就研發出一種真菌發酵製成的天然紅色色素,不僅靠實驗室就能生產,還有望取代素食者不能接受、從胭脂蟲萃取的「胭脂紅」?
【贊助】支持優質飲食知識頻道,一起成為餐桌上最懂吃的人!
https://pay.soundon.fm/podcasts/eedfec2c-dabc-492e-8737-a0a05b50c2c7
哪裡聽👂(想第一時間收到更新通知,記得按下訂閱喔):
🎧 SoundOn_ https://reurl.cc/KADaoM
🎧 Spotify_ https://reurl.cc/W3W2n7
🎧 KKBOX_ https://reurl.cc/YOQA24
🎧 Listen Notes_ https://reurl.cc/O0DO7R
🎧 Google_ https://reurl.cc/rgXe8Z
🎧 Apple_ https://reurl.cc/VEe9Ly
延伸閱讀
▶實驗室也能做出天然色素?真菌發酵的純素紅色色素,可望取代胭脂紅
▶發現天然食用藍色素新來源!食品巨頭瑪氏可望將其商業運用、替代人工色素!
▶紅色色素竟從「蟲蟲」提煉而來!不管害怕或吃素,新種蕃薯為你帶來新選擇!